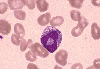

|    |

全登録症例数:225
全登録画像数:1755
全登録画像数:1755
MDSにみられる主な血球の異形成(形態異常)は以下のものがある。
1)赤芽球系:①核の出芽様突出、②核間橋形成、③核融解(崩壊)像、④多
核化、⑤巨赤芽球様変化、⑥環状鉄芽球、⑦空胞化、⑧PAS陽性赤芽球
2)顆...
(続きを読む) MDSにみられる主な血球の異形成(形態異常)は以下のものがある。
1)赤芽球系:①核の出芽様突出、②核間橋形成、③核融解(崩壊)像、④多
核化、⑤巨赤芽球様変化、⑥環状鉄芽球、⑦空胞化、⑧PAS陽性赤芽球
2)顆粒球系:①低分葉(偽ペルゲル核異常)、②過分葉、③顆粒減少・脱顆
粒、④粗大顆粒、⑤環状核好中球、⑥PO陰性好中球
3)巨核球系:①低分葉微小巨核球、②未分葉核巨核球、③分離多核巨核
球など. 微小巨核球の同定基準は、リンパ球の2倍大か前骨髄球大か2倍
まで(朝長ら.1989)を基準にするのも一法と思われる。
本例は大球性正色素性貧血のもと若干の赤血球形態異常がみられ、骨髄では芽球の増加はないものの、赤芽球系を中心に巨核球系にも形態異常(10%以下)がみられた。MCVの高値と赤芽球系に軽度の形態異常がみられたためMDS-RAを疑った。
(たたむ)
1)赤芽球系:①核の出芽様突出、②核間橋形成、③核融解(崩壊)像、④多
核化、⑤巨赤芽球様変化、⑥環状鉄芽球、⑦空胞化、⑧PAS陽性赤芽球
2)顆...
(続きを読む) MDSにみられる主な血球の異形成(形態異常)は以下のものがある。
1)赤芽球系:①核の出芽様突出、②核間橋形成、③核融解(崩壊)像、④多
核化、⑤巨赤芽球様変化、⑥環状鉄芽球、⑦空胞化、⑧PAS陽性赤芽球
2)顆粒球系:①低分葉(偽ペルゲル核異常)、②過分葉、③顆粒減少・脱顆
粒、④粗大顆粒、⑤環状核好中球、⑥PO陰性好中球
3)巨核球系:①低分葉微小巨核球、②未分葉核巨核球、③分離多核巨核
球など. 微小巨核球の同定基準は、リンパ球の2倍大か前骨髄球大か2倍
まで(朝長ら.1989)を基準にするのも一法と思われる。
本例は大球性正色素性貧血のもと若干の赤血球形態異常がみられ、骨髄では芽球の増加はないものの、赤芽球系を中心に巨核球系にも形態異常(10%以下)がみられた。MCVの高値と赤芽球系に軽度の形態異常がみられたためMDS-RAを疑った。
(たたむ)
■症例詳細データ
| FAB分類 | > 骨髄異形成症候群 (MDS) > 不応性貧血 (RA) |
|---|---|
| 性別 | 男 |
| 年齢 | 70-74 |
| 取得年代 | 1995-1999 |
| 主訴 | 貧血。 |
| 既往歴 | 5年前、痔の手術。 |
| 現病歴 | 貧血を指摘され、当科へ紹介となり三血球の減少より入院になる。 |
| 検査所見 | WBC 2,100/μl (St2, Seg65, Ly28, Mo2, Eo3%, 芽球+)、RBC 180万/μl、Hb 6.6g/dl、Ht 20.9%、 PLT 6.4万/μl、MCV 116.1fl、MCH 36.6pg、MCHC 31.5%、NCC 21.6万/μl、Mgk 62.5/μl (芽球3%) TP 6.6g./dl、LD 435IU/l、CRP 3.9mg/dl、Ca 8.1mg/dl |
| 末梢血所見 | 白血球減少(2,100/μl)にて芽球様は全視野に2個認めた。好中球の減少(1,407/μl)がみられ、好酸球に輪状核がみられた。貧血は大球性正色素性貧血で、その形態は大小不同性で、多染性赤血球や奇形赤血球を認めた。 |
| 骨髄所見 | 正形成の骨髄像にてM/E比は1.2と赤芽球が優位であった。芽球は3%で、異形成として赤芽球系に2核や非対称核が、巨核球の一部に小型の巨核球がみられた。 |
| 細胞化学所見 | 赤芽球はPAS染色に陰性で、Fe染色では環状鉄芽球は認めなかった。 |
| 形態診断 | 大球性正色素性貧血(MCV116.1fl)のもと若干の赤血球形態異常がみられ、骨髄では芽球の増加はないものの、赤芽球系を中心に巨核球系にも形態異常がみられた。 MCVの高値と赤芽球系に軽度の形態異常がみられたためMDS-RAを疑った。 |
| 免疫学的所見 | 未施行。 |
| 分子生物学的所見 | 46,XY,-10,+der (1)(1;10)(p11;p11)[16] 46,XY[4] |
| リンパ節所見 | 未施行。 |
| 臨床診断 | 汎血球減少とMCVの高値、骨髄における赤芽球、巨核球の異形成よりMDSの不応性貧血(RA)と診断された。 |